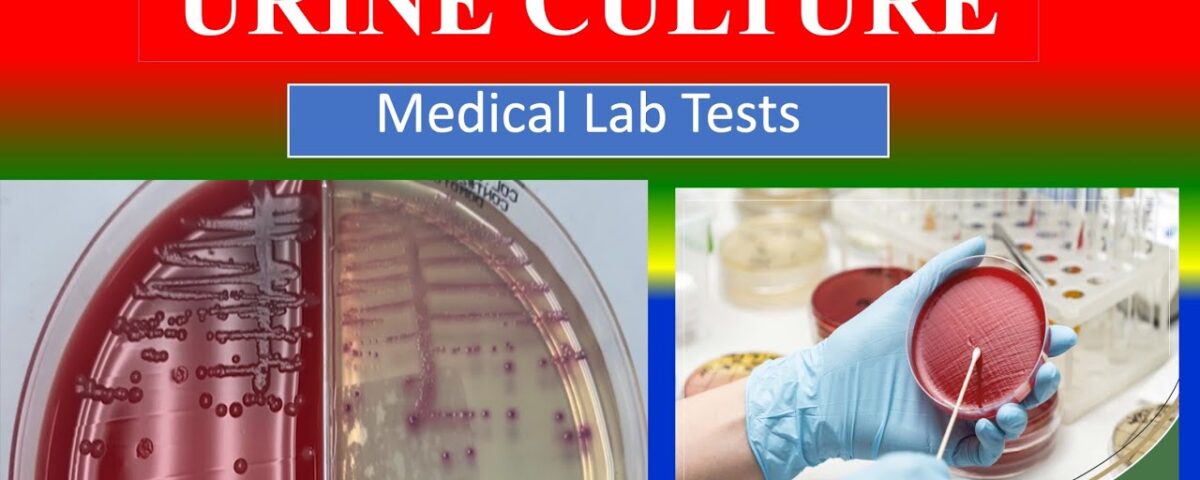

Urine Culture Test: Purpose, Procedure, Cost, and Result Explained

Hormone Blood Test: Types, Preparation, and Understanding Your Results
November 7, 2025
Benefits of blood sugar investigation in fasting
November 24, 2025When it comes to diagnosing infections and understanding the root cause of urinary problems, the urine culture test plays a crucial role. This diagnostic test helps doctors detect bacteria, yeast, or other microorganisms that may be causing infections in the urinary tract. The urine culture sensitivity and urine culture and sensitivity tests are among the most common investigations recommended by healthcare professionals when a patient experiences symptoms like burning during urination, frequent urination, or cloudy urine. Visiting the best diagnostic center in gurugram ensures accurate and timely results, helping patients receive the right treatment based on their condition. Understanding the purpose, procedure, and meaning of the urine culture and sensitivity test report can help patients interpret their results better and take appropriate action.

What Is a Urine Culture Test?
A urine culture test is a microbiological test performed to detect the presence of harmful microorganisms in the urine. Normally, urine inside the bladder is sterile, meaning it does not contain bacteria or fungi. However, when microorganisms enter the urinary tract through the urethra, they can multiply and cause infections known as urinary tract infections (UTIs). The urine culture and sensitivity test helps identify these microorganisms and determines which antibiotics can effectively kill them. This combination of urine culture sensitivity and antibiotic testing ensures that the patient receives the most effective treatment.
Purpose of a Urine Culture Test
The primary goal of a urine culture test is to detect the cause of urinary tract infections and to evaluate whether the treatment being provided is working effectively. Doctors may recommend this test if a patient shows symptoms like:
- Burning sensation during urination
- Frequent urge to urinate
- Cloudy, foul-smelling urine
- Blood in urine
- Pain in the lower abdomen or back
The urine culture sensitivity and urine culture and sensitivity tests are also used to monitor patients who have a history of recurrent UTIs or those with kidney disorders. The urine culture and sensitivity test report not only identifies the specific microorganism but also provides the culture and sensitivity test normal values, helping doctors compare whether the bacterial growth is within or above the expected range.
Importance of Urine Culture Sensitivity
The urine culture sensitivity aspect of the test is critical because it determines which antibiotics are most effective against the bacteria found in the sample. Without this part of the test, it would be difficult to select the right antibiotic, leading to prolonged infections or antibiotic resistance. The urine culture and sensitivity process helps doctors tailor treatment plans precisely. The urine culture and sensitivity normal values indicate no significant bacterial growth, meaning the urine is sterile and the person is free from infection.
In contrast, abnormal urine culture and sensitivity test reports show the presence of bacteria such as E. coli, Klebsiella, or Proteus species. These results guide physicians in selecting antibiotics that can specifically target the infection-causing microorganism.
Urine Culture Test Procedure
Understanding the urine culture test procedure is essential for accurate results. The test generally involves the following steps:
- Sample Collection – The patient is asked to provide a midstream urine sample in a sterile container. This helps avoid contamination from skin bacteria.
- Transport to Laboratory – The urine sample must be sent to the lab within two hours of collection.
- Inoculation on Culture Media – The laboratory technician spreads a small amount of urine on culture plates containing nutrient media.
- Incubation – The plates are incubated at a specific temperature for 24 to 48 hours to allow bacterial growth.
- Examination of Colonies – After incubation, bacterial colonies are examined, counted, and identified.
- Sensitivity Testing – In the next step, different antibiotics are applied to the culture plate to determine which antibiotic can inhibit or kill the bacteria.
This entire urine culture test procedure is conducted under sterile conditions to avoid false results. The urine culture and sensitivity process ensures accurate diagnosis by identifying both the organism and its response to antibiotics.
Understanding Urine Culture and Sensitivity Normal Values
Once the test is completed, the laboratory provides a detailed urine culture and sensitivity test report. This report contains information about bacterial growth and antibiotic sensitivity. The urine culture and sensitivity normal values generally indicate “no growth” or “insignificant growth,” meaning fewer than 10,000 colony-forming units per milliliter (CFU/mL) of urine.
However, if the urine culture and sensitivity results show bacterial growth of more than 100,000 CFU/mL, it indicates an active infection. These culture and sensitivity test normal values serve as a reference for healthcare providers to decide whether treatment is necessary. A deviation from urine culture and sensitivity normal values means the bacteria are multiplying rapidly, requiring prompt medical attention.

How to Read a Urine Culture and Sensitivity Test Report
The urine culture and sensitivity test report typically includes several columns detailing bacterial names, colony counts, and antibiotic response. Here’s how you can interpret it:
- Organism Identified: The bacteria responsible for the infection, such as E. coli, Enterococcus faecalis, or Pseudomonas aeruginosa.
- Colony Count: The number of bacterial colonies found in the urine.
- Antibiotic Sensitivity: The list of antibiotics tested and their effectiveness—marked as Sensitive (S), Intermediate (I), or Resistant (R).
Normal urine culture and sensitivity results mean no significant bacterial growth, while abnormal results point toward infection. The urine culture sensitivity section indicates which medications will work best. When reviewing the urine culture and sensitivity test report, doctors pay attention to both bacterial identification and antibiotic response to ensure the most effective therapy is prescribed.
Preparation Before the Urine Culture Test Procedure
Before undergoing the urine culture test procedure, patients should follow some guidelines to ensure accurate results:
- Drink adequate water to produce a sufficient urine sample.
- Avoid taking antibiotics before the test, as they can affect bacterial growth.
- Clean the genital area properly before collecting the sample.
- Collect the midstream urine and not the first few drops.
Following these steps helps ensure that the urine culture and sensitivity test results are not contaminated and accurately reflect the patient’s condition.
Urine Culture and Sensitivity in Different Age Groups
The urine culture and sensitivity test is not limited to adults. It is equally important for children, infants, and the elderly. In children, it helps detect congenital urinary tract problems, while in adults, it helps identify infections caused by bacteria resistant to antibiotics. Elderly individuals are more prone to infections due to weakened immunity, and a urine culture and sensitivity test report assists doctors in selecting safe and effective antibiotics.
Culture and Sensitivity Test Normal Values Explained
The culture and sensitivity test normal values are critical for differentiating between contamination and infection. Generally, the absence of bacterial growth in the urine culture and sensitivity test report means the urinary system is healthy. However, even minor deviations from culture and sensitivity test normal values should not be ignored, especially if symptoms persist.
The urine culture and sensitivity and urine culture sensitivity tests are crucial for evaluating infection severity and guiding treatment strategies. Knowing the culture and sensitivity test normal values helps track treatment progress and identify recurring infections early.
Cost of Urine Culture Test
The cost of the urine culture test varies depending on the laboratory and region. In most cities, it ranges between ₹400 to ₹1,000. Some advanced laboratories also provide an express service where the urine culture and sensitivity test report is delivered within 24 hours. The investment in this test is minimal compared to the benefits it provides in detecting and treating infections accurately.

Factors Affecting Urine Culture Sensitivity Results
Several factors can influence the urine culture sensitivity results:
- Improper Sample Collection: Contamination from skin bacteria can lead to false-positive results.
- Antibiotic Use Before Test: Taking antibiotics before the urine culture test procedure can inhibit bacterial growth.
- Delay in Sample Processing: If urine is not tested within a few hours, bacteria may multiply, altering results.
Hence, following the proper urine culture test procedure ensures that the urine culture and sensitivity results accurately reflect the infection status.
Interpreting Abnormal Urine Culture and Sensitivity Test Report
When a urine culture and sensitivity test report indicates bacterial growth, the doctor assesses the type of organism, its quantity, and antibiotic sensitivity. If the bacteria are resistant to multiple antibiotics, stronger medications or a combination therapy may be recommended. The urine culture sensitivity results act as a roadmap for doctors to choose the best antibiotic treatment plan.
An abnormal urine culture and sensitivity test report should never be ignored, as untreated infections can lead to complications such as kidney damage or sepsis. Regular monitoring with urine culture and sensitivity tests helps ensure that the infection is completely eradicated.
When to Repeat the Urine Culture Test
In some cases, doctors may advise repeating the urine culture test after a few days of treatment. This follow-up test ensures that the prescribed antibiotics are working effectively. If the infection persists, the urine culture sensitivity test helps doctors modify the treatment plan. The urine culture and sensitivity normal values achieved after therapy confirm that the infection has resolved completely.

Conclusion
The urine culture test is one of the most effective diagnostic tools for identifying urinary tract infections and guiding appropriate treatment. By performing a urine culture and sensitivity test, healthcare professionals can pinpoint the exact microorganism responsible and determine the best antibiotic therapy. For those seeking accurate and timely results, opting for a urine culture test in gurgaon at a trusted diagnostic center ensures precise detection and effective management of infections. Understanding the urine culture test procedure, the urine culture and sensitivity normal values, and interpreting the urine culture and sensitivity test report are essential for both patients and doctors to ensure accurate diagnosis and timely treatment.
Whether you’re experiencing mild urinary symptoms or recurring infections, the urine culture sensitivity test provides a clear picture of what’s happening inside your urinary tract. With proper sample collection, timely testing, and adherence to treatment, patients can achieve healthy and infection-free urinary systems. Knowing the culture and sensitivity test normal values helps you stay informed about your health and enables your doctor to offer personalized medical care.
FAQS
What is a urine culture test?
A urine culture test is a laboratory test used to detect bacteria, fungi, or other microorganisms in urine. It helps identify urinary tract infections and determine the most effective antibiotic treatment through urine culture sensitivity testing.
Why is a urine culture and sensitivity test done?
Doctors recommend a urine culture and sensitivity test to diagnose urinary tract infections (UTIs), find the specific organism causing infection, and choose the right antibiotic based on the urine culture sensitivity results.
What is the urine culture test procedure?
The urine culture test procedure involves collecting a midstream urine sample in a sterile container, sending it to a lab, culturing it on nutrient media, incubating it, and then performing antibiotic sensitivity testing to find the best treatment option.
What are urine culture and sensitivity normal values?
Urine culture and sensitivity normal values usually indicate “no bacterial growth” or less than 10,000 colony-forming units per milliliter (CFU/mL), showing the absence of infection.
How much does a urine culture test cost?
The urine culture test cost typically ranges from ₹400 to ₹1,000, depending on the laboratory and location. Some labs offer faster reporting options for an additional fee.
How do you read a urine culture and sensitivity test report?
A urine culture and sensitivity test report shows the name of the microorganism, colony count, and antibiotic response marked as Sensitive (S), Intermediate (I), or Resistant (R). Normal reports show no bacterial growth, while abnormal ones confirm infection.